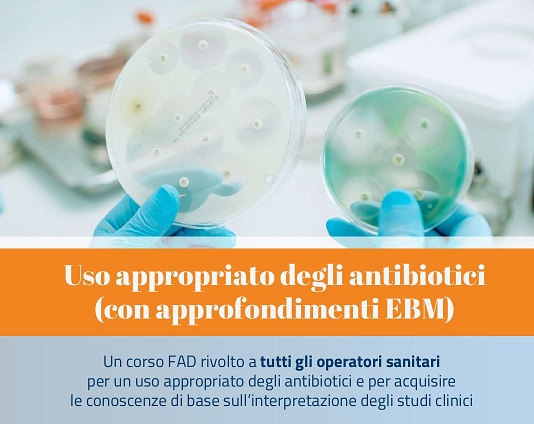

Regione Calabria-Progetto Nazionale di Farmacovigilanza COSIsiFA- Corsi FAD-ECM per operatori sanitari
-Corso FAD dal titolo "Revisione della Terapia e Riduzione dei farmaci nell'anziano". rivolto a tutti gli operatori sanitari della Regione.
-Corso FAD “Uso appropriato degli antibiotici (con approfondimenti EBM)”, rivolto a tutti gli operatori sanitari della Regione.
I corsi sono fruibili attraverso la piattaforma SAEPE al link http://www.fad.saepe.it/ con validità attualmente fino al 31.12.2025, accreditati ECM con 12 Crediti Formativi. La consultazione dei Corsi disponibili è possibile anche sul sito web www.crfvcalabria.it, nella sezione Formazione _Corsi FAD.